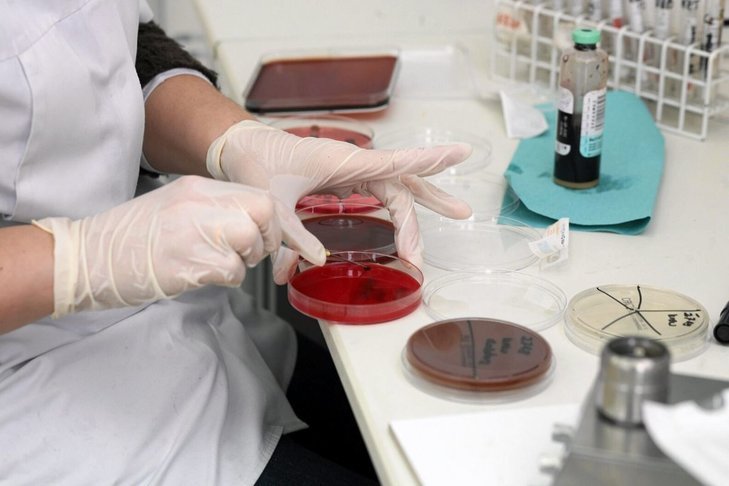
Przed debiutem, w roku 2016 OncoArendi Therapeutics miało 1,6 mln zł przychodów z działalności operacyjnej. Strata netto wyniosła wtedy 2,4 mln zł.

Jest kwiecień 2018 r. Na warszawskiej giełdzie debiutuje OncoArendi Therapeutics, spółka specjalizująca się w poszukiwaniu, rozwoju i komercjalizacji nowych leków stosowanych w terapii chorób zapalnych i nowotworowych. Nikt nie podejrzewa jeszcze, że za dwa lata będzie w centrum uwagi mediów i opinii publicznej.
REKLAMA
Giełdowy debiut
Kurs akcji OncoArendi Therapeutics (OAT) wzrósł na otwarciu notowań o 6,6 proc. do 30,9 zł. Cenę emisyjną akcji ustalono na 29 zł, co wtedy dawało wycenę całej spółki na prawie 400 mln zł.Jak na firmę, która niczego jeszcze nie produkuje i nie zarabia, to sporo.
W ofercie publicznej na konta inwestorów trafiło 2 mln akcji, czyli 14,6 proc. podwyższonego kapitału, co łącznie dało 58 mln zł.
W ofercie publicznej na konta inwestorów trafiło 2 mln akcji, czyli 14,6 proc. podwyższonego kapitału, co łącznie dało 58 mln zł.
Obecna wycena OAT to 10,2 zł za akcję, czyli blisko trzykrotnie mniej niż w dniu debiutu. Widać zatem, że inwestorzy raczej nie wierzą w jej obietnice i potencjał.
Co ciekawe, szum medialny również jej specjalnie nie przeszkadza. W sierpniu ub. roku płacono za akcję OAT raptem ok. 10 zł, czyli podobnie jak dzisiaj.
Czym jest OAT?
OncoArendi Therapeutics (OncoArendi) mówi o sobie, że jest firmą biotechnologiczną, której celem jest opracowanie i rozwój nowych leków drobno-cząsteczkowych do zastosowania w terapii chorób o największej potrzebie klinicznej.Firma podaje, że pracuje nad nowymi lekami w kilku dziedzinach. Najbardziej zaawansowany obecnie projekt dotyczy potencjalnego nowego leku na astmę.
Zajmuje się też cząsteczkami, które mają pomóc w terapii nowotworów, na co ma trafiać finansowanie pozyskiwane z różnych źródeł.
Niestety trudno to w jakikolwiek sposób zweryfikować, jako że efekty pracy spółki są praktycznie niemierzalne, a inwestorzy mogą żyć głównie nadzieją i obietnicami. To, jak widać po wycenie, raczej im nie wystarcza. Tym bardziej, że projekty są mocno spóźnione, co wyklucza wszelką ich sensowną weryfikację.
Również fora giełdowe nie kryją obaw. "Inwestorzy giełdowi jak dotąd robią jako dawcy kapitału. Jedyni zarobieni, to zarząd i wszyscy wybitni specjaliści, produkujący towar, na który póki co nie ma chętnych" - pisze jeden z posiadaczy akcji.
Inny dodał, że "OAT to firma bez wartości, bo jej przychody to zero zł".
"Jakie zero, jest grubo na minusie" - pisze kolejny.
Tu trzeba dodać, że faktycznie spółka głównie generuje straty - i w 2018 i 2019 r. po ponad 4 mln zł rocznie.
Przed debiutem, w roku 2016 OncoArendi Therapeutics miało 1,6 mln zł przychodów z działalności operacyjnej, choć większość z nich była przychodami z tytułu dotacji, co do dziś się nie zmieniło. Strata netto wyniosła wtedy 2,4 mln zł. Obecnie jest większa.
Z czysto finansowego punktu widzenia inwestora jest to dość kuriozalne i gdyby nie milionowe dotacje, firma nie miałaby prawa istnieć, bo od lat niczego nie sprzedaje, ani nie produkuje.
W tej grze jest najbogatszy Polak
Ale cała sprawa ma drugie dno, bo największym inwestorem w OncoArendi Therapeutics jest najbogatszy Polak Michał Sołowow, który w 2015 r., za pośrednictwem funduszu Ipopema 112 FIZAN, zainwestował w nią ok. 12 mln zł, co daje mu ponad 30 proc. akcji. Jak podawała przed czterema laty kielecka "Gazeta Wyborcza", CBA wkroczyło wtedy do spółek Sołowowa, które dostawały dotacje z Narodowego Centrum Badań i Rozwoju. Pod zarzutem korumpowania szefa NCBiR zatrzymano wieloletniego współpracownika kieleckiego miliardera - Krzysztofa K.Spory, blisko 10 proc. pakiet posiada też spółka prezesa Marcina Szumowskiego, brata ministra zdrowia, który próbuje tłumaczyć się z różnych ostatnich doniesień.
Szacunki mediów wskazują na to, że spółka otrzymała od NCBIR aż ponad 300 mln zł dotacji łącznie.